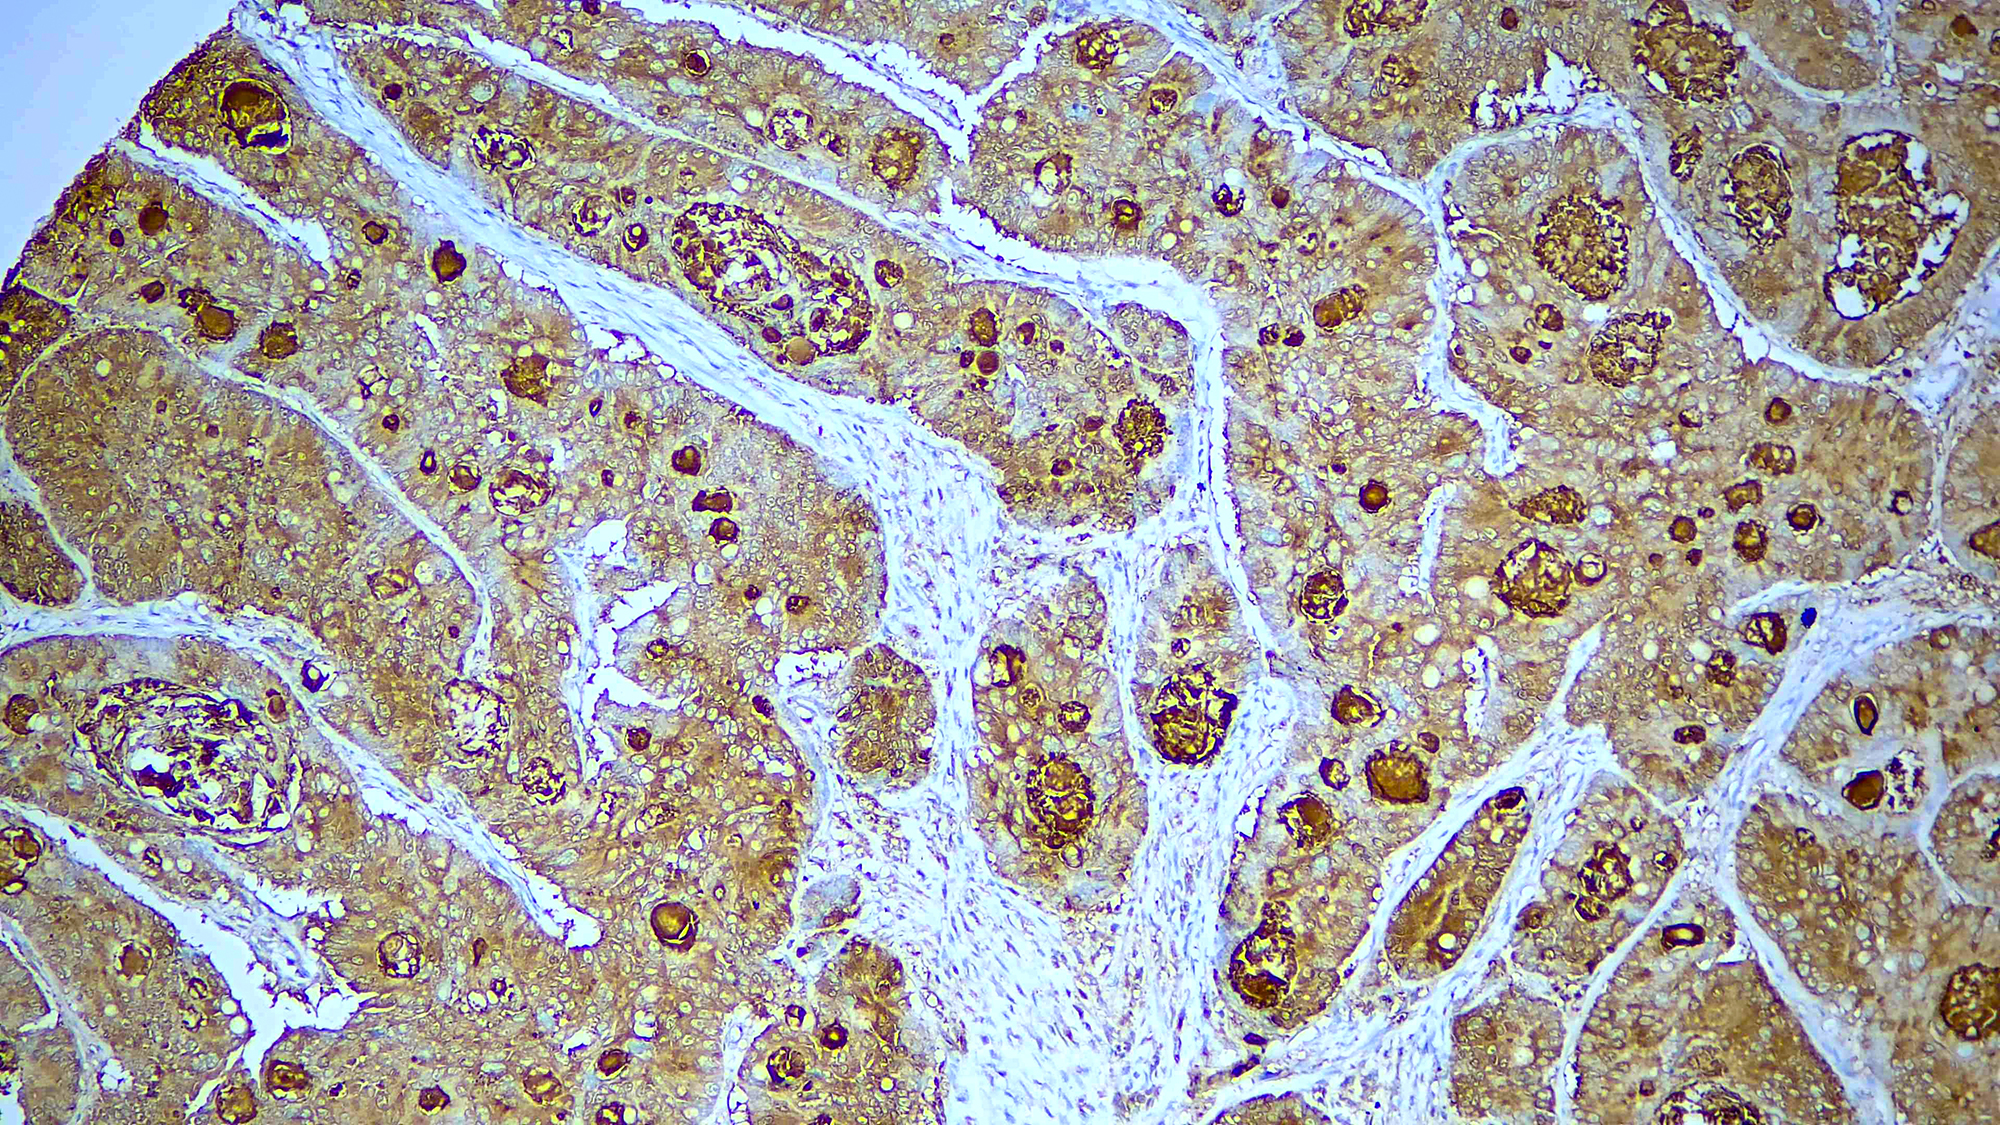
CEACAM5 1 Formalin fixed paraffin embedded human esophageal carcinoma tissue stained with CEACAM5

CEACAM are a family of Cell surface glycoproteins implicated in Cell adhesion and signaling as well as promotion of cancer progression and metastasis and are promising targets for novel anticancer agents. Among CEACAM, new therapeutics targeting CEACAM are of relevance in lung cancer. CEACAM5 is overexpressed in many epithelial tumors compared with normal tissue, and its presence appears to facilitate tumorigenesis and metastasis. Specifically, CEACAM5 is expressed to greater extent in non-squamous NSCLC than in squamous NSCLC( SQ-NSCLC) but is not expressed in normal lung tissue, making it an attractive target for antibody-drug conjugate (ADC) therapy. Therapy ADCs are an emerging therapeutic class for the treatment of patients.
CEACAM5
Catalog No: RMAB118R-
Categories: Primary Antibodies, RUO - For U.S. Market, RUO - Outside U.S. Market
Description
Additional information
| Catalog No. | RMAB118R, RMPD118R |
|---|---|
| Clone | DBRRM2.85 |
| Isotype | IgG, kappa |
| Immunogen | Recombinant human CEA protein fragment |
| Species | Rabbit |
| Cellular Localization | cell surface |
| Positive Control Tissue | Colon carcinoma |
| Pretreatment | EDTA Buffer pH 8.0 (Manual/ Montage) |
| Incubation & Temperature | 30 min @ RT |
| Intended Use | RUO |
| Detection System | PolyVue™ Plus – Two Step Detection System or Montage PolyVue Plus™ Auto Detection System for Montage 360 System or HighLighter core kit for HighLighter Staining System |
| Description/Type | FFPE, Rabbit Monoclonal Antibody |
| Format | Purified immunoglobulin |
DATASHEETS & SDS
DATASHEETS & SDS
| Download Datasheet |
REFERENCES
REFERENCES
- i) Mod Pathol 2021;34:710
- ii) Hum Pathol 2022;125:97
- iii) Hum Pathol 2023;138:62
- iv) Int J Cancer Biomed Res 2023;7:13
Reviews (0)
Only logged in customers who have purchased this product may leave a review.

Reviews
There are no reviews yet.